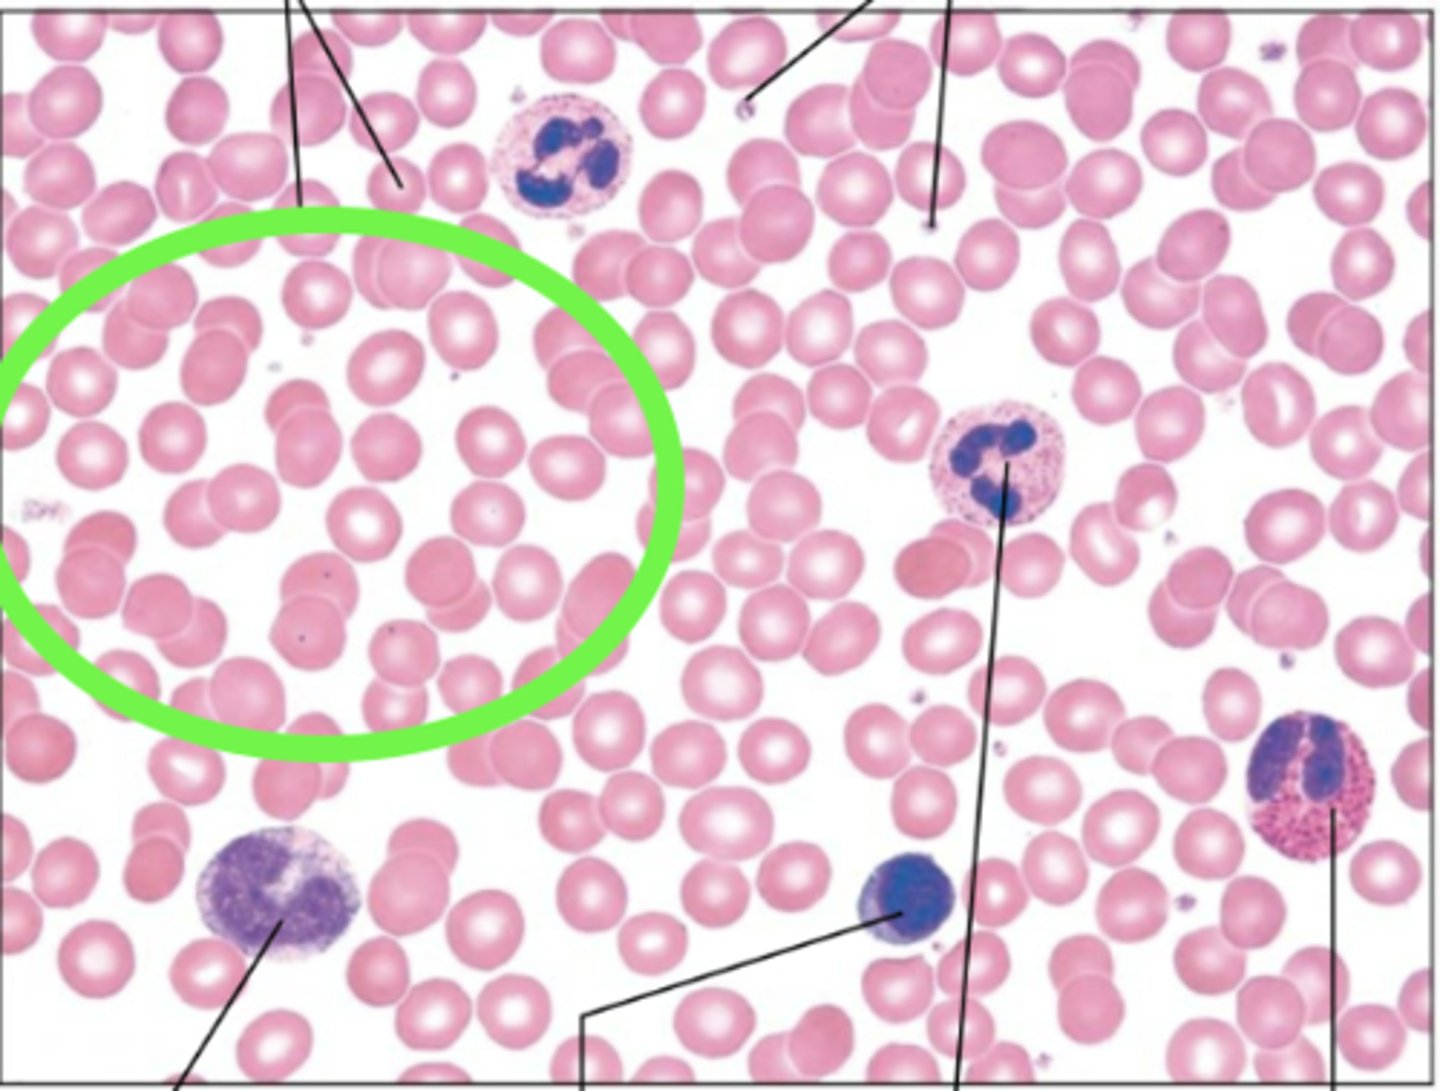
knowt flashcard image
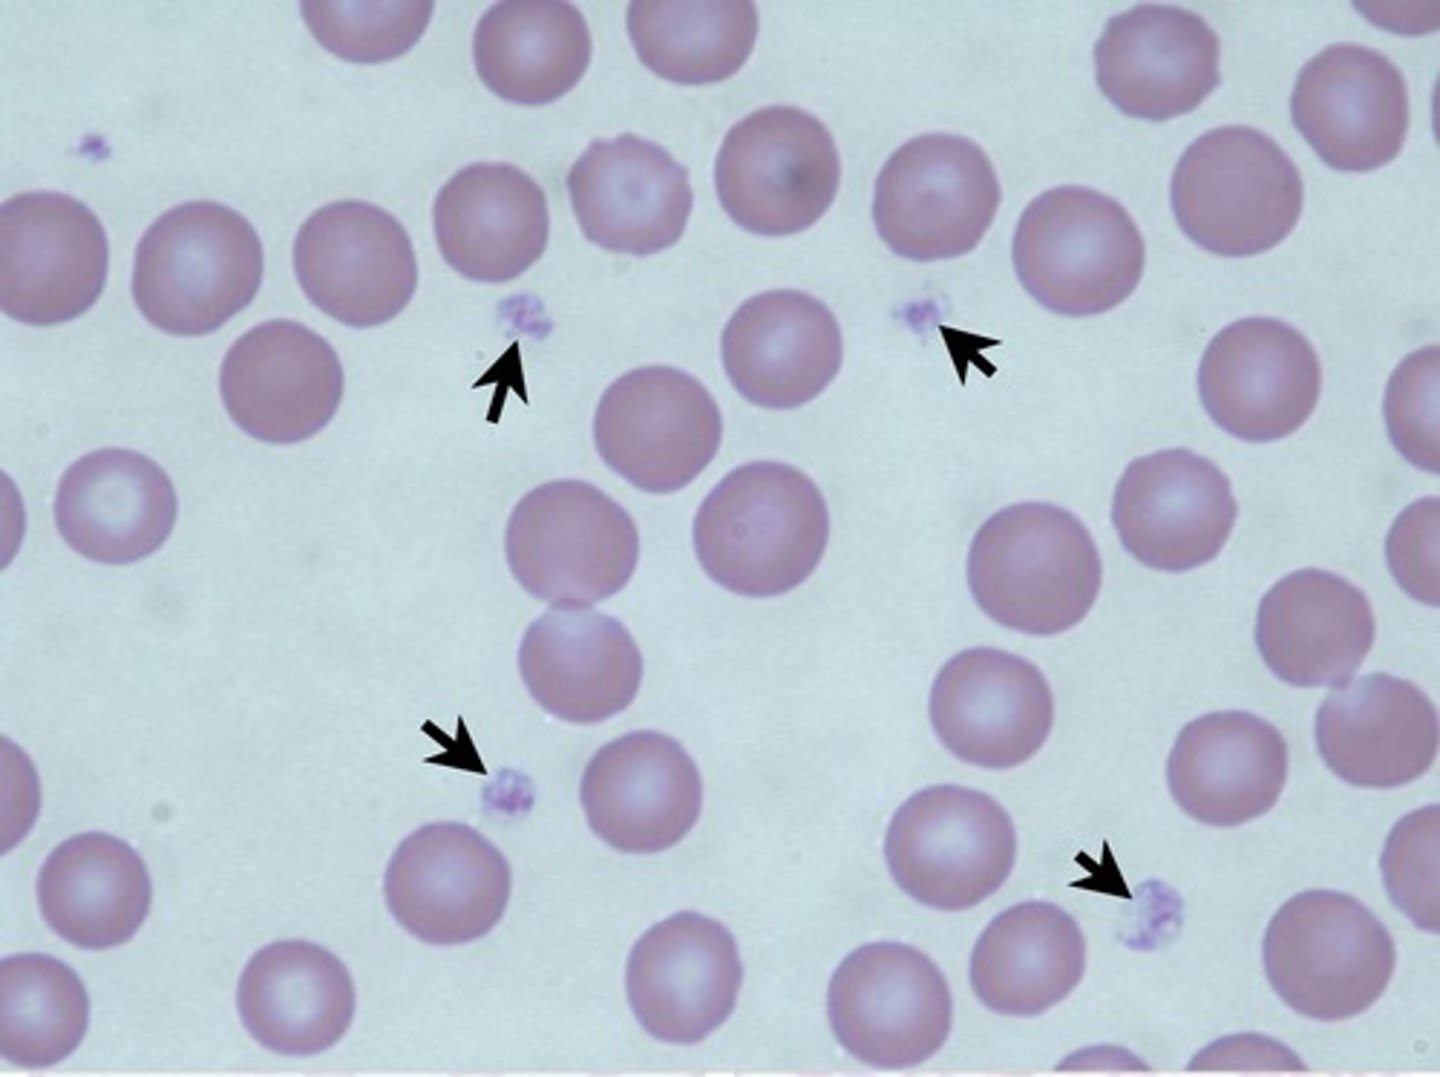
knowt flashcard image
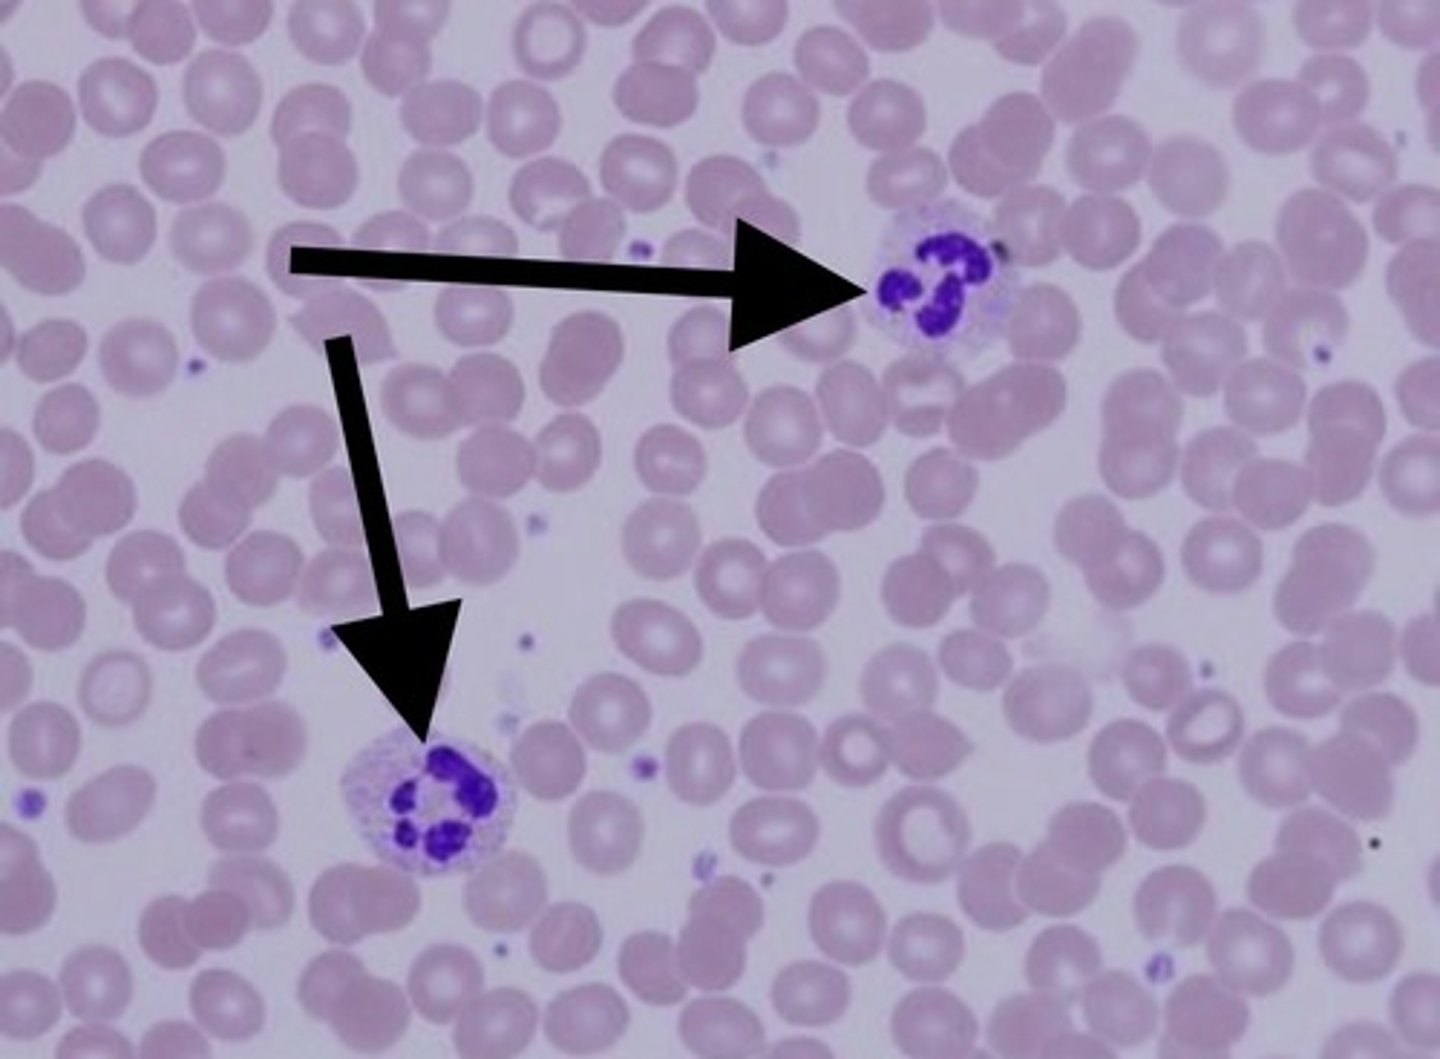
knowt flashcard image
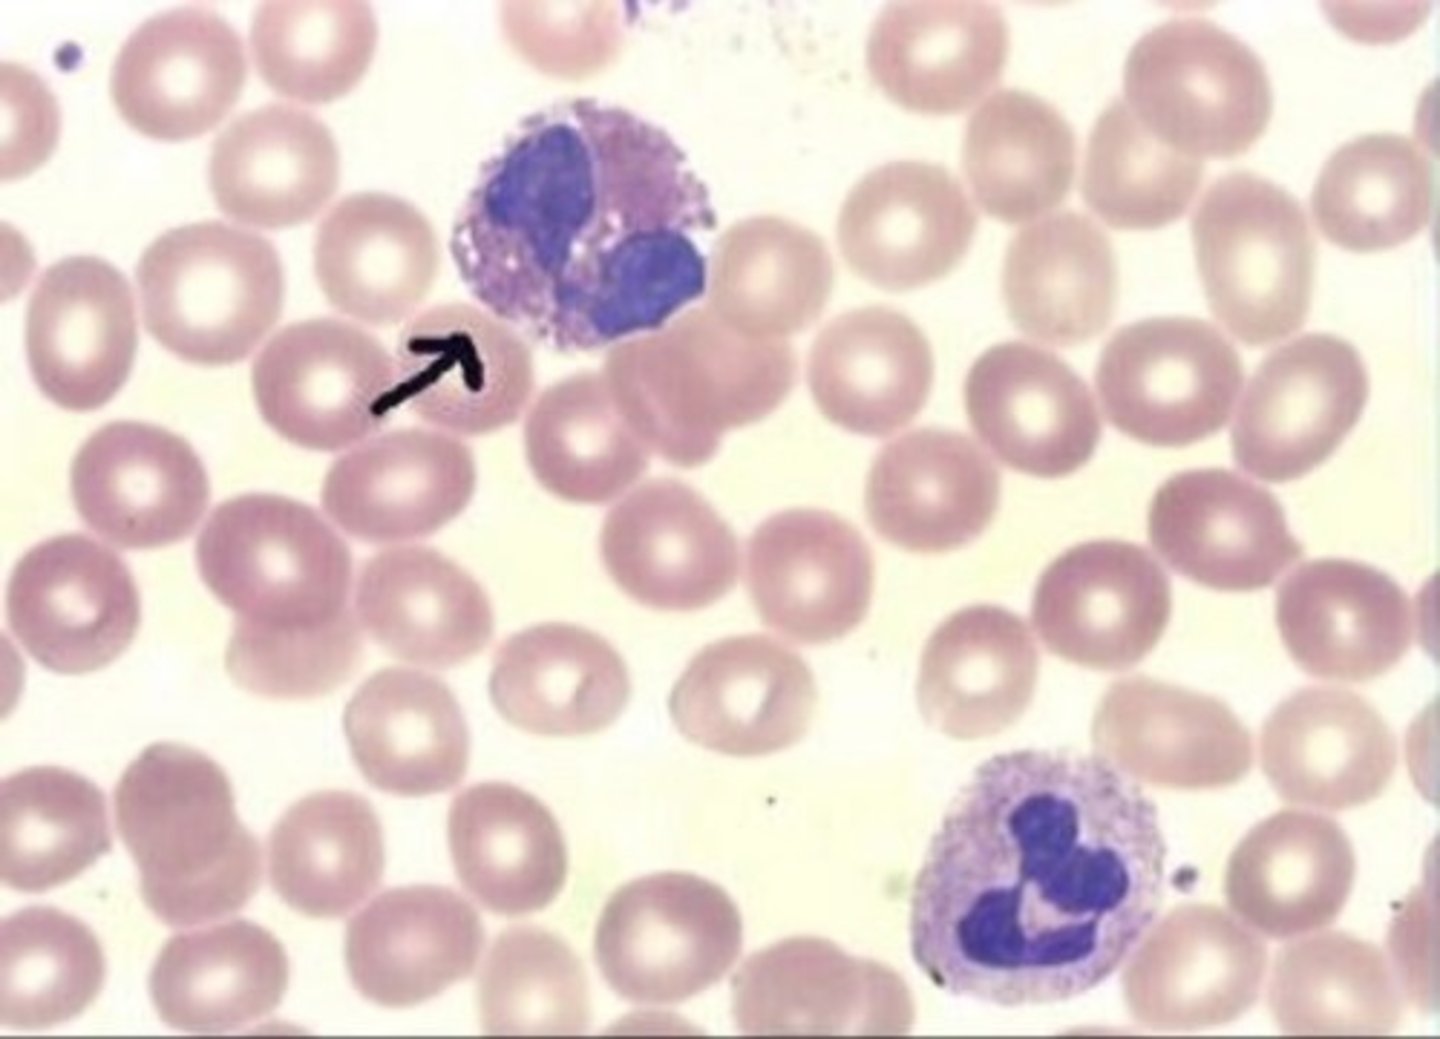
knowt flashcard image
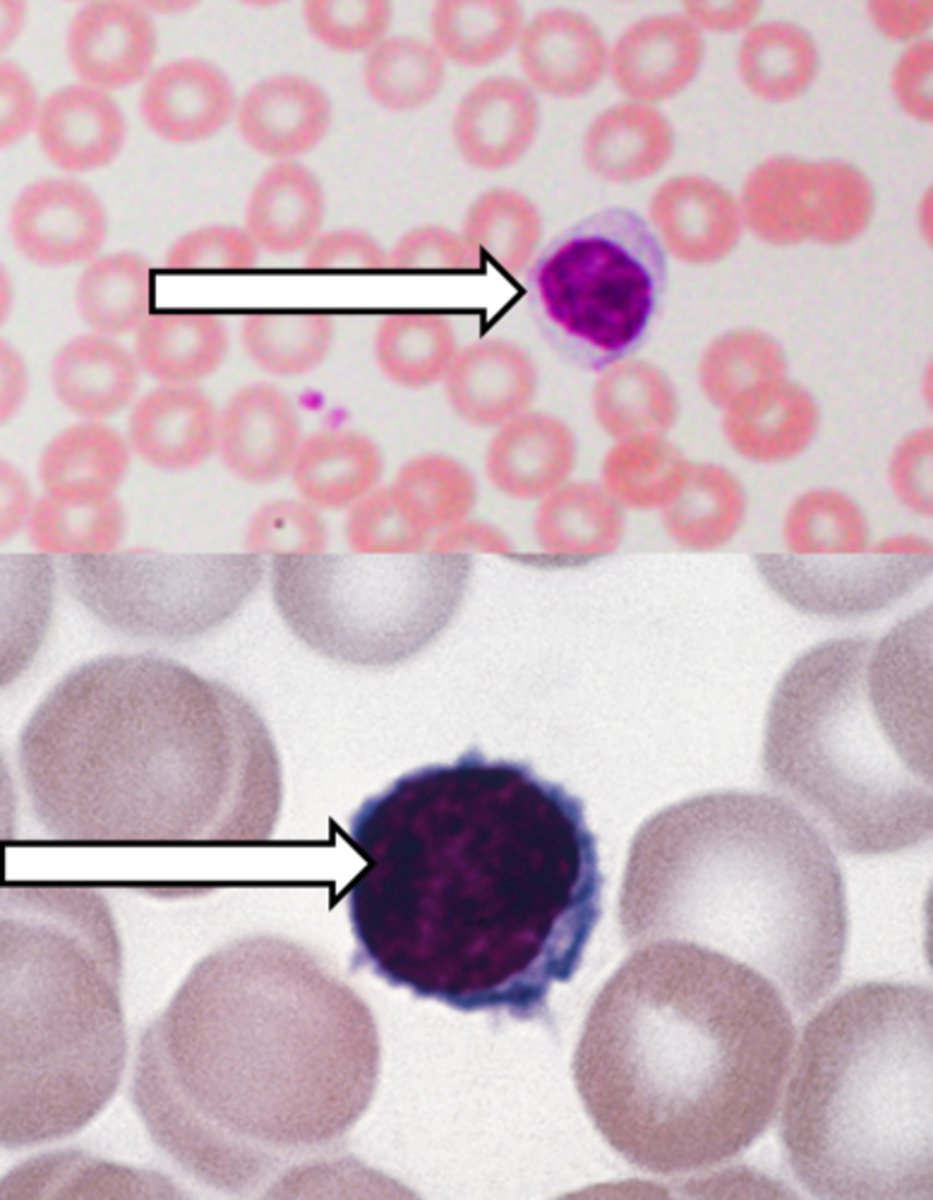
knowt flashcard image

1/122
Looks like no tags are added yet.
Name | Mastery | Learn | Test | Matching | Spaced | Call with Kai |
|---|
No analytics yet
Send a link to your students to track their progress
Pineal gland

Hypothalamus

Infundibulum of hypothalamus

Pituitary gland (hypophysis)

Anterior pituitary

Posterior pituitary (neurohypophysis)

Thyroid gland

Right lobe of thyroid gland

Left lobe of thyroid gland

Isthmus of thyroid gland

Parathyroid glands

Adrenal gland

Adrenal cortex

Adrenal medulla

Pancreas

Pancreas Head

Pancreas Body

Pancreas Tail

Ovaries

Testes
E

Thymus

Left lobe thymus

Right lobe thymus

Thymic arteries

Thyroid gland histology

Thyroid follicle

Follicular cells

Parafollicular cells (C cells)

Pancreas histology

Pancreatic acini

Pancreatic islet (islet of Langerhans)

Pituitary gland (hypophysis) histology

Anterior pituitary (adenohypophysis) Histology

Pars intermedia Histology

Posterior pituitary Histology

Human blood Smear Histology

Erythrocytes Histology
Platelets Histology
Granulocytes
neutrophils, eosinophils, basophils
Neutrophils Histology
Eosinophils Histology
Basophils Histology

Agranulocytes
lymphocytes and monocytes
Lymphocytes Histology
Monocytes

Fibrous pericardium

Fibrous pericardium sheep heart

Pericardial cavity

Parietal pericardium

Visceral pericardium

Mediastinum

Right atria

Right atria sheep heart
1

Left atria

Left atria sheep heart

Right auricles

Right auricles sheep heart

Left auricles

Left auricles sheep heart

Right ventricle

Right ventricle sheep heart

Left ventricle

Left ventricle sheep heart

Apex

Apex sheep heart

Base

Base sheep heart

Superior vena cava

Superior vena cava sheep heart

Ligamentum arteriosum

Inferior vena cava

Inferior vena cava sheep heart

Aorta

Ascending aorta sheep heart

Aortic arch

Pulmonary trunk

Pulmonary trunk sheep heart

Right pulmonary arteries
3

Left pulmonary arteries

Right pulmonary veins
4

Left pulmonary veins

Coronary sulcus

Coronary sulcus sheep heart

Anterior interventricular sulcus

Anterior interventricular sulcus sheep heart

Posterior interventricular sulcus

Posterior interventricular sulcus sheep heart

Endocardium

Endocardium sheep heart

Myocardium

Myocardium sheep heart

Epicardium

Epicardium sheep heart

Fossa ovalis

Pectinate muscles

Trabeculae carneae

Interventricular septum

Interventricular septum sheep heart

Pulmonary semilunar valve

Pulmonary semilunar valve sheep heart
